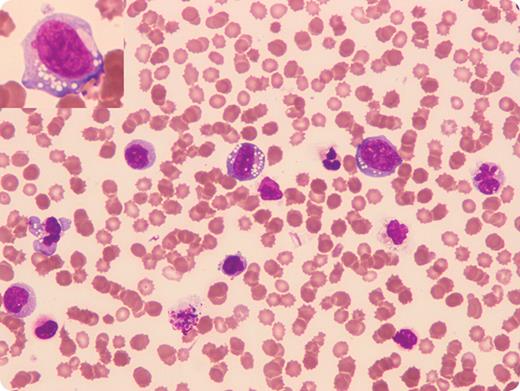
A 9-year-old boy was diagnosed with stage III ALK-positive anaplastic large cell lymphoma (ALCL) with no evidence of bone marrow and central nervous system disease. / Seven months later he had a normocytic anemia (hemoglobin 79 g/L), severe thrombocytopenia (platelets 15 × 109/L), and leukocytosis (white blood cell count 50.8 × 109/L). The automated differential showed neutrophils 28.5 × 109/L, monocytes 13.2 × 109/L, and “other” cells 4.6 × 109/L. The peripheral blood smear (shown) contained large immature cells with basophilic cytoplasm and prominent cytoplasmic vacuolation. Karyorrhexis, pyknosis, and karyolysis were also seen in the large immature cells. Red blood cell morphology showed numerous echinocytes (also known as burr cells), which were likely a consequence of renal failure (creatinine 162μM, urea 12.9mM). / Flow cytometric immunophenoptyping on the peripheral blood showed that 55% of the cells expressed CD30, HLA-DR, and partial CD13. The cells expressing bright CD30 also expressed CD25. A diagnosis of leukemic transformation of ALCL was made. Microscopic review of the peripheral smear clarified the “automated differential” that was inaccurately reported.

A 9-year-old boy was diagnosed with stage III ALK-positive anaplastic large cell lymphoma (ALCL) with no evidence of bone marrow and central nervous system disease.
Seven months later he had a normocytic anemia (hemoglobin 79 g/L), severe thrombocytopenia (platelets 15 × 109/L), and leukocytosis (white blood cell count 50.8 × 109/L). The automated differential showed neutrophils 28.5 × 109/L, monocytes 13.2 × 109/L, and “other” cells 4.6 × 109/L. The peripheral blood smear (shown) contained large immature cells with basophilic cytoplasm and prominent cytoplasmic vacuolation. Karyorrhexis, pyknosis, and karyolysis were also seen in the large immature cells. Red blood cell morphology showed numerous echinocytes (also known as burr cells), which were likely a consequence of renal failure (creatinine 162μM, urea 12.9mM).
Flow cytometric immunophenoptyping on the peripheral blood showed that 55% of the cells expressed CD30, HLA-DR, and partial CD13. The cells expressing bright CD30 also expressed CD25. A diagnosis of leukemic transformation of ALCL was made. Microscopic review of the peripheral smear clarified the “automated differential” that was inaccurately reported.
A 9-year-old boy was diagnosed with stage III ALK-positive anaplastic large cell lymphoma (ALCL) with no evidence of bone marrow and central nervous system disease.
Seven months later he had a normocytic anemia (hemoglobin 79 g/L), severe thrombocytopenia (platelets 15 × 109/L), and leukocytosis (white blood cell count 50.8 × 109/L). The automated differential showed neutrophils 28.5 × 109/L, monocytes 13.2 × 109/L, and “other” cells 4.6 × 109/L. The peripheral blood smear (shown) contained large immature cells with basophilic cytoplasm and prominent cytoplasmic vacuolation. Karyorrhexis, pyknosis, and karyolysis were also seen in the large immature cells. Red blood cell morphology showed numerous echinocytes (also known as burr cells), which were likely a consequence of renal failure (creatinine 162μM, urea 12.9mM).
Flow cytometric immunophenoptyping on the peripheral blood showed that 55% of the cells expressed CD30, HLA-DR, and partial CD13. The cells expressing bright CD30 also expressed CD25. A diagnosis of leukemic transformation of ALCL was made. Microscopic review of the peripheral smear clarified the “automated differential” that was inaccurately reported.
Many Blood Work images are provided by the ASH IMAGE BANK, a reference and teaching tool that is continually updated with new atlas images and images of case studies. For more information or to contribute to the Image Bank, visit http://imagebank.hematology.org.